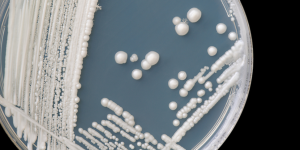
В США набирает обороты смертельная грибковая инфекция, от которой нет лекарства

отметили
72
человека
в архиве
Россия вошла в тройку самых читающих стран мира
 rbc.ru
rbc.ru
Россия вошла в тройку самых читающих стран мира: 59% россиян заявили, что хотя бы раз в неделю обращаются к книге. Реальные продажи книжной продукции, однако, по-прежнему падают, хотя и не так быстро, как раньшеГеография читателейРоссия наряду с Китаем и Испанией вошла в тройку самых читающих стран ...
15 комментариев
проблема (1)
отметили
57
человек
в архиве
В СССР в 1976 году микроволновые печи были запрещены из-за их вредного воздействия на здоровье. В отношении них было проведено множество исследований. Запрет был снят в начале 90-х после Перестройки
 newsinfo.ru
newsinfo.ru
Микроволны:1. Ускоряют структурный распад продуктов.2. В молоке и зерновых культурах создают канцерогенные вещества.3. Изменяют элементарный состав продуктов питания, вызывая расстройства пищеварения.4. Изменяют химию пищи, что может привести к сбоям лимфатической системы и разрушению способности ор...
проблема (13)
отметили
65
человек
в архиве
Томские школьники взяли три золота на международных соревнованиях Роботраффик в Израиле
 edurobots.ru
edurobots.ru
Грандиозной победы добились школьники из Томска на VIII Международном чемпионате по роботраффику, который состоялся 23 марта 2017 года в университете Технион (Израиль).Призовые места на соревновании заняли Андрей Деев и Дмитрий Киреев под руководством тренера Алексея Черных. Ребята занимаются робото...
проблема (3)
отметили
52
человека
в архиве
[Процесс пошёл] В Подмосковье новые школы построят по модульному принципу
 rg.ru
rg.ru
Строить школы в Подмосковье теперь будут по модульному принципу. Первая модульная школа на 600 мест появится через год в Серпухове, затем аналогичные здания построят в Сергиевом Посаде, Волоколамске, Ивантеевке и Шатуре. Из-за нехватки школ 55 тысяч подмосковных детей учатся во вторую смену. Ликвида...
отметили
53
человека
в архиве
Минздрав отказался от анализов мочи и крови при медосмотрах
 izvestia.ru
izvestia.ru
Минздрав оценил экономический эффект от затрат на проведение диспансеризации. По данным министерства, вложенные в поддержание здоровья россиян финансы могут вернуться в одиннадцатикратном размере. В то же время ведомство решило со следующего года исключить анализы мочи и крови из программы обязатель...
проблема (1)
отметили
82
человека
в архиве
Решение наследников братьев Стругацких о свободном доступе к произведениям Стругацких
 facebook.com
facebook.com
Андрей СтругацкийВ одной старой песенке пелось: «И в борьбе с зелёным змеем побеждает змей!».
Вот так же и у нас: попытались мы бороться с пиратством в интернете, но пиратство, увы, победило! Законопослушные сайты выполнили нашу просьбу убрать книги Стругацких из свободного доступа, но, к сожале...
проблема (1)
отметили
62
человека
в архиве
Рошаль сделал сенсационные заявления перед Путиным
 regnum.ru
regnum.ru
Москва, 21 марта 2017, 18:18 — REGNUM В России фактически отсутствует единая структура управления здравоохранением, при этом медицинская сфера страдает от хронического недофинансирования. Об этом 21 марта заявил профессор, знаменитый педиатр и общественный деятель, директор НИИ неотложной детской хи...
проблема (1)
отметили
48
человек
в архиве
В США набирает обороты смертельная грибковая инфекция, от которой нет лекарства
 tech.onliner.by
tech.onliner.by
До формата эпидемии пока далеко, однако «внутрибольничная инфекция», вызываемая дрожжевым грибком Candida auris, в США набирает обороты. Если неделю назад зараженными считались чуть более 30 человек, то на сегодня это число достигло 53, пишет New Scientist. А частота смертельных исходов достигает 60...
проблема (1)
отметили
61
человек
в архиве
Введенные в России запрет на курение в общественных местах и устрашающие картинки на пачках относятся к самым неэффективным методам борьбы с курением. Лучше всего работают материальные стимулы
 rbc.ru
rbc.ru
C 17 марта на сигаретных пачках, продающихся в России и других странах Евразийского экономического союза, должны размещаться более устрашающие картинки, чем прежде. По идее, изображения поврежденных курением человеческих органов должны отвадить население от пагубной привычки. Сюжеты будут те же, что...
проблема (1)
отметили
55
человек
в архиве
«Ребята, я поняла: мы как-то неправильно воспитали у вас гражданскую позицию»
 zona.media
zona.media
«Команда Навального» «ВКонтакте» распространила запись, сделанную школьником из Брянской области во время воспитательной беседы с директором школы. Разговор состоялся после того, как одного из учеников вызвали в полицию. Как утверждают сторонники оппозиционера, школьник вступил в сообщество, где обс...
отметили
69
человек
в архиве
Молодые мозги суперстариков. Ученые выяснили, что у некоторых людей мозг до старости остается «молодым»
 gazeta.ru
gazeta.ru
«Суперстарики» (superagers) — термин, придуманный неврологом из Чикаго Марселем Месуламом. Так он назвал пожилых людей, чьи память и внимательность не просто лучше, чем должны быть в их годы, а не уступают памяти и внимательности молодых людей 20–30 лет.Некоторые старики в тестах на внимание и памят...
отметили
59
человек
в архиве
[Цифры] Искусственный интеллект от Google научился выявлять рак груди с точностью 89%
 hightech.fm
hightech.fm
Исследователи из Google Research научили алгоритм выявлять метастазы в лимфоузлах молочной железы с точностью 89% — на 16% эффективнее врачей-патологов.Для обучения алгоритма ученые использовали базу изображений с результатами биопсии пациентов медицинского центра при Университете Неймегена в Нидерл...
отметили
62
человека
в архиве
Минздрав Танзании грозится опубликовать списки геев
 korrespondent.net
korrespondent.net
Гомосексуализм в Танзании является уголовным преступлением.Заместитель министра здравоохранения Танзании Хамиси Кигвангалла в ходе спора о природе геев в Twitter пригрозил опубликовать списки имен гомосексуалистов. Секс между двумя мужчинами в Танзании является уголовным преступлением и наказывается...
проблема (11)
отметили
90
человек
в архиве
В России создали лекарство от рака и проверили его в космосе. Генно-инженерный препарат от всех видов и стадий злокачественных опухолей пациенты могут получить через три-четыре года
 izvestia.ru
izvestia.ru
В Государственном научно-исследовательском институте особо чистых препаратов Федерального медико-биологического агентства (ФМБА) России завершаются доклинические испытания «Белка теплового шока» — лекарства, которое может совершить революцию в онкологии. Это принципиально новое средство для лечения ...
проблема (1)
отметили
55
человек
в архиве
МГУ ликвидировал диссовет, который отказался рассматривать диссертацию Мединского
 kommersant.ru
kommersant.ru
Ректор Московского государственного университета (МГУ) Виктор Садовничий объявил о закрытии созданного на базе исторического факультета диссертационного совета, который решил не рассматривать материалы диссертации министра культуры Владимира Мединского. Господин Садовничий добавил, что, согласно зак...
проблема (1)
отметили
46
человек
в архиве
Российский видеоролик о ПДД победил на международном кинофестивале
 tass.ru
tass.ru
МОСКВА, 27 февраля. /ТАСС/. Российский социальный видеоролик «Челюсти» победил на Всемирном кинофестивале по безопасности дорожного движения в Женеве в номинации «Инновации в процессе образования безопасности дорожного движения». Об этом ТАСС сообщила официальный представитель МВД Ирина Волк.
«С...
проблема (3)
отметили
60
человек
в архиве
В США отменили закон Обамы о туалетах для трансгендеров в школах
 ria.ru
ria.ru
ВАШИНГТОН, 23 фев – РИА Новости. Администрация президента США Дональда Трампа отменила предписание его предшественника Барака Обамы о туалетах для трансгендеров в государственных школах, следует из заявления пресс-службы Минюста.Ранее администрация Обамы выпустила директиву для государственных школ,...
отметили
45
человек
в архиве
Москва отменила надбавки врачам за ученую степень и почетное звание
 rbc.ru
rbc.ru
Московские власти отменили обязательные надбавки к окладу, которые получают врачи за наличие ученой степени или почетного звания. Как сообщает RNS, это следует из приказа столичного департамента здравоохранения от 26 декабря 2016 года №1033. В нем говорится, что размеры доплат теперь устанавливаются...
проблема (4)
отметили
64
человека
в архиве
Образование для кастрюль: вместо биологии и географии в школах введут историю Майдана и скотоводство
 antifashist.com
antifashist.com
Министерство образования Украины, работающее под американским патронатом, готовит новую школьную программу для отпрысков майдаунов. Чтобы не напрягать мозг под кастрюльками, главное учебное ведомство предлагает объединить в общую дисциплину физику, химию, биологию, географию, астрономию и экологию. ...
проблема (5)
отметили
57
человек
в архиве
Применение нашей группировки в Сирии позволило решить геополитическую задачу – прервать цепь «цветных революций» - Шойгу
 function.mil.ru
function.mil.ru
Сегодня Министр обороны России генерал армии Сергей Шойгу выступил с лекцией на открытии II Всероссийского молодёжного форума «Международное военно-политическое и военно-экономическое сотрудничество: современные тенденции» в Московском государственном институте международных отношений (университете)...
проблема (4)
отметили
45
человек
в архиве
отметили
45
человек
в архиве
Вместо споров в интернете: при российских школах могут открыть сеть политических клубов
 ru.rt.com
ru.rt.com
Правительство России просят открыть при российских средних школах единую всероссийскую сеть политических дискуссионных клубов. Это предложение направляет в кабмин (есть в распоряжении RT) экспертно-аналитический центр РАНХиГС под руководством Николая Калмыкова. Авторы инициативы полагают, что такая ...
проблема (2)
отметили
66
человек
в архиве
Нам не до учёбы: конгрессмены предложили ликвидировать Министерство образования США
 ru.rt.com
ru.rt.com
Американские конгрессмены предложили ликвидировать Министерство образования США. Соответствующий законопроект внёс на рассмотрение конгресса США член палаты представителей Томас Мэсси при поддержке семи коллег-республиканцев. Авторы документа объясняют свою инициативу тем, что образовательная систем...
проблема (1)
отметили
74
человека
в архиве
Fancy Bears: WADA разрешает спортсменке принимать запрещённый препарат в течение 8 лет
 russian.rt.com
russian.rt.com
Хакерская группировка предоставила RT документы, из которых следует, что стендовый стрелок из Канады Синтия Мейер получила два терапевтических исключения на ежедневное применение тамоксифена с разницей в шесть лет: первое — в 2009 году на пять лет, второе — в 2015 году на три года. Причём 51-летней ...
отметили
54
человека
в архиве
Совфед: будем пытаться вернуть систему ГОСТов
 russian.rt.com
russian.rt.com
Зампред комитета Совета Федерации по аграрно-продовольственной политике и природопользованию Ирина Гехт заявила, что в 2017 году в Россию может вернуться система ГОСТов.Соответствующее заявление было сделано в ходе пресс-конференции «Готов ли отечественный производитель к отмене контрсанкций?» в пре...

![[Процесс пошёл] В Подмосковье новые школы построят по модульному принципу](/story_images/517000/1490329984_24_63799.jpg)

![[Цифры] Искусственный интеллект от Google научился выявлять рак груди с точностью 89%](/story_images/516000/1488987763_100_23864.jpg)











